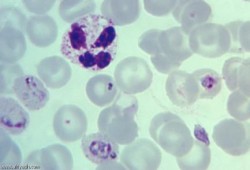
"النحس" .. الملاريا تصيب 26 شخصاً بأسوان.. و700 شخص تحت الفحص

الخميس ٦ ذو القعدة ١٤٤٧ هـ - 23 أبريل 2026 م
أخبار النافذة
الحرس الثوري يهدد بتدمير نفط الخليج إذا دخل الحرب ضد إيران
تمديد هدنة ترامب مع إيران يفضح تعثر التفاوض ويُبقي الحصار مفتوحًا ويكشف كلفة الحرب على واشنطن
إصلاح لا يصل إلى المقاعد.. ضوابط جديدة لاختيار رؤساء الشركات المملوكة للدولة
حزب الله يعلن إسقاط مسيرات إسرائيلية وتدمير دبابة ميركافا
مجلس العلاقات الخارجية || ترامب يمدد هدنة حرب إيران وسط تصعيد في مضيق هرمز
هل تسبب الهواتف أورام الدماغ؟
مونديال 2026 بلا حدود.. نسخة تغيّر وجه كرة القدم
4 مشكلات صحية مميتة يتزايد خطر حدوثها في الصباح